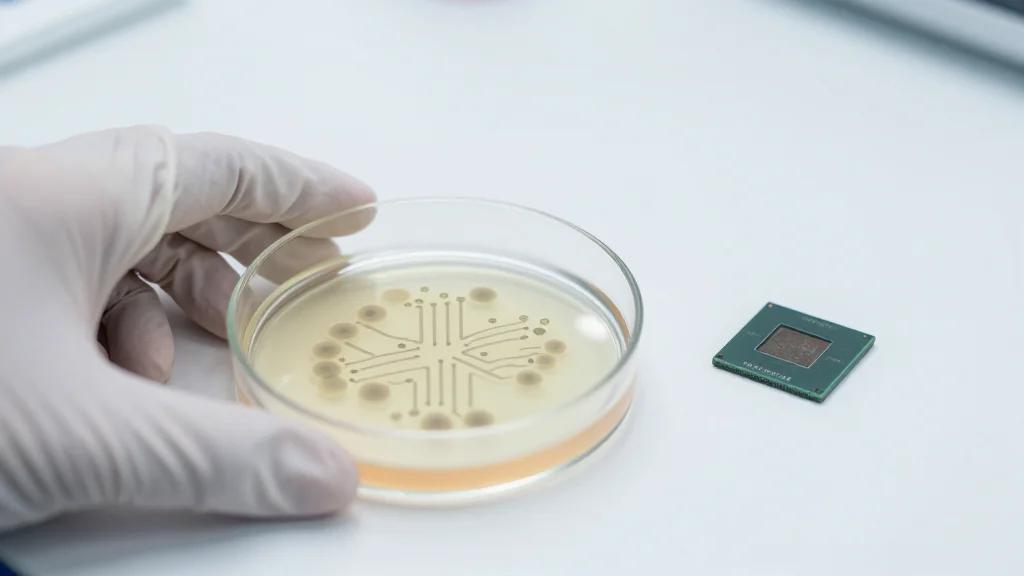
Developing a Risk-Scoring Tool for Artificial Intelligence-Enabled Biological Design

A Sofia Kourtesis DJ Kicks Is on the Way
Colombian producer Sofia Kourtesis will release a new DJ Kicks mix on March 27 through K7, opening the set with her first original track “Los Poemas No Siempre Riman.” The 21‑track compilation blends four of her own songs with exclusive contributions from artists such as Jon Hopkins, Aphex Twin, Axel Boman and Laurence Guy. Kourtesis describes the mix as a journey of emotion, tension and release, reflecting the influence of the iconic DJ Kicks series on her DJing philosophy. The release follows her 2023 album Madres and 2024 Volver EP.

U.S. Air Force Buys Chimera FPV Drones for Special Unit
The U.S. Air Force has awarded a sole‑source, firm‑fixed‑price contract to Oak Grove Technologies for its Chimera small unmanned aerial systems, fulfilling an urgent requirement of the 1st Special Operations Wing at Hurlburt Field. The procurement includes Chimera FPV drones...

How the Hedge Strategy Will Impact the US Navy’s Future Capabilities
The U.S. Navy’s newly announced Hedge Strategy seeks to rebuild its surface fleet around lethal, modular and affordable platforms. By emphasizing flexibility and cost‑effectiveness, the plan aims to halt the chronic schedule slips and budget overruns that have plagued recent...

Al-Ula Marks Middle East ATC First
Al‑Ula International Airport in Saudi Arabia has become the Middle East’s first fully remote air traffic control facility, with controllers operating from a centre in Jeddah 550 km away. The digital tower uses high‑definition cameras, sensors and a 4K 360° videowall...

Ore Energy Pilots 100-Hour Iron-Air BESS at EDF Lab in France
Ore Energy completed Europe’s first 100‑hour iron‑air long‑duration energy storage pilot at EDF Lab les Renardières, demonstrating multi‑day grid‑connected operation. The test, part of the EU‑backed StoRIES program, ran for several months under varied load profiles and seasonal conditions, moving...

Moldova. EU – Yes; CIS – No; Unirea – Not This Time
Moldova announced its formal exit from the Commonwealth of Independent States, signaling a decisive break from a key Russian‑linked institution. At the same time, Chişinău is accelerating its integration with the European Union under President Maia Sandu’s pro‑Western agenda. Public...

We’re in a Trade-Down Economy, and Ulta Is Winning
Consumer confidence has fallen to a decade low, prompting a trade‑down in spending as Americans cut big‑ticket indulgences and shift toward essentials. Even high‑income households are frequenting discount retailers like Walmart and Costco, reflecting broader budget pressure. Ulta Beauty’s hybrid...

What Oscar History Predicts for This Year's Best Picture Nominees
The Envelope analyses this year’s Best Picture slate by matching each nominee to historic Oscar winners, drawing parallels in genre, theme, and narrative structure. Guillermo del Toro’s "Frankenstein" echoes the fantastical romance of 2018’s "The Shape of Water," while Ryan Coogler’s...

6 Essential Desert Reads
The article curates six essential books that capture the Southwest’s desert spirit, ranging from Mary Austin’s 1903 lyrical essays to Forrest Gander’s 2024 poetic meditation. Classics like Edward Abbey’s *Desert Solitaire* introduced the region’s fragile beauty to a national audience,...

NIH Researchers Identify Four-Marker Blood Test That May Improve Early Pancreatic Cancer Detection
NIH‑backed researchers reported a four‑marker blood test that improves early detection of pancreatic ductal adenocarcinoma. The panel combines CA19‑9, THBS2, ANPEP and PIGR, achieving 91.9% overall accuracy at a 5% false‑positive rate and 87.5% sensitivity for stage I‑II disease. The study...

David’s Sling Air Defense System Validates Combat Lessons in a Recent Test Campaign
Israel’s David’s Sling medium‑to‑long‑range interceptor completed a rigorous test campaign that incorporated real‑time combat lessons from Operation Rising Lion. The trials, run by the Israeli Missile Defense Organization with U.S. MDA support, validated a suite of upgrades that improve interception of missiles, rockets,...

Uranium Exposure in Children Near Johannesburg Mine Tailings Raises Public Health Concerns
Researchers measured uranium in soil and children’s hair near Johannesburg gold‑mine tailings, revealing markedly higher exposure than a non‑mining reference site in Durban. Median hair uranium was 17.07 µg/kg versus 8.12 µg/kg, while residential soil showed a 10% concentration increase. Girls and...

Sky to Offer ‘World-First’ Major Streamers Bundle
Sky announced a world‑first bundle that combines Netflix, Disney+, Hayu and HBO Max under a single Sky TV subscription. The partnership adds Disney+ immediately, HBO Max becomes available on 26 March, and Hayu’s reality‑TV lineup joins in July. All services are delivered through...

European Energy Wins 116MW UK Solar CFDs
European Energy secured Contracts for Difference for three solar farms in the UK, totaling 116 MWp, at a strike price of £65.23 /MWh. The projects—Church Farm, Manor Farm and Old Hall Farm—were awarded in Allocation Round 7a, which delivered 14.7 GW of clean power...

Japan Hands Philippines Radars to Keep Closer Eye on China
Japan officially handed over five coastal radar systems to the Philippines under its 2023 Official Security Assistance program. The equipment, which includes surveillance, communications and support components, is designed to enhance the Philippine Navy’s maritime domain awareness and support ISR,...

AI, Defence and Energy Transition to Drive India’s Next Capex Wave: Chetan Ahya
Morgan Stanley’s Chetan Ahya says India is entering a new capex wave driven by a global industrial cycle revival, stronger non‑tech exports, and three structural trends: AI‑related infrastructure, higher defence spending, and the energy‑transition push. He notes that the Indian...

LiveU Spotlights Three Broadcast Priorities at NAB Show 2026
At NAB Show 2026, LiveU introduced its most extensive IP‑video ecosystem, centered on the new LU900Q field unit with native LiveU IQ connectivity. The company also displayed LiveU Nexus, a universal gateway that normalises IP feeds, and LiveU Studio, a...

New Medicaid Work Rules Likely To Hit Middle-Aged Adults Hard
Starting in January, new Medicaid work requirements will compel about 20 million low‑income adults in 42 states to log at least 80 hours of work, volunteering, or schooling each month to retain coverage. The rules disproportionately affect middle‑aged adults, especially women...

End of Enhanced Obamacare Subsidies Puts Tribal Health Lifeline at Risk
Tribal health‑insurance programs that rely on ACA premium subsidies are facing a funding crisis after the enhanced tax credits expired at the end of 2025. Premiums have surged, forcing tribes like Fort Peck and Blackfeet to limit enrollment and risk...

ING Groep NV Sells 64,648 Shares of GE Aerospace $GE
ING Groep NV trimmed its GE Aerospace holding by 38.3%, selling 64,648 shares and leaving a 104,299‑share position worth roughly $31.4 million. The reduction came as other institutions, notably Norges Bank, Jennison Associates, Vanguard, Lazard and Geode Capital, expanded their stakes,...

Andhra Pradesh Chief Secretary Directs Power Utilities to Ensure Uninterrupted Supply During Summer
Andhra Pradesh chief secretary K Vijayanand ordered power utilities to guarantee uninterrupted, 24 × 7 electricity during the upcoming summer. He emphasized rapid commissioning of the Polavaram Hydel Power Project, with the first seven 80‑MW units slated for July 2027, delivering 960 MW of clean...

Ørsted Takes Delivery of First Hornsea 3 Monopiles
Ørsted has received the first six monopiles for the Hornsea 3 offshore wind project at Teesside, marking the start of on‑site works for what will become the world’s largest offshore wind farm. The steel foundations, supplied by Haizea, weigh about 1,670 tonnes...

Guidance: Military Low Flying: MOD Sponsored Air Exercises
The UK Ministry of Defence (MOD) has been continuously publishing and updating a detailed schedule of military low‑flying air exercises from early 2021 through early 2026. Each entry lists a specific week‑long window during which training flights are authorised, reflecting...

BioRestorative Concludes Phase II BRTX-100 Trial Enrolment for cLDD
BioRestorative Therapies announced completion of patient enrollment for its Phase II BRTX‑100 trial in chronic lumbar disc disease, enrolling 99 subjects at 15 U.S. sites. The double‑blind, sham‑controlled study randomizes participants 2:1 to receive an autologous hypoxically cultured mesenchymal stem cell...

TotalEnergies Cuts Buybacks as Low Oil, Gas Prices Weigh on Profits
TotalEnergies announced a 62% reduction in its Q1 share buyback, lowering the program to $750 million after a fourth‑quarter adjusted net income of $3.8 billion fell 13% year‑on‑year. The cut reflects weaker oil and gas prices that offset a 215% surge in...

“Unleash the Kraken,” Bellows Skull and Bones, Which Somehow Still Exists
Ubisoft has launched the "Eye of the Beast" season for its troubled open‑world pirate title Skull and Bones, introducing a multi‑phase Kraken boss and a new Corvette support vessel. The update also revives the Founding Event to celebrate the game’s...

HERC for Modernisation, Efficiency in Power Distribution System
Haryana Electricity Regulatory Commission (HERC) is pushing for modernisation and efficiency in the state’s power distribution network, urging companies to cut AT&C losses and boost consumer satisfaction. At a public hearing, Chairman Nand Lal Sharma highlighted the need for network...

New GSMA Report Shows Low-Band Spectrum Is Required to Tackle the Rural Connectivity Gap and Help Unlock Rural Economic Growth
The GSMA’s new report finds that allocating additional sub‑1 GHz spectrum is essential for closing the rural digital divide. Adding just 50 MHz of low‑band spectrum can lift rural 4G coverage by 7 percentage points and 5G coverage by 11 percentage points, while also...

Cold War Battlescruiser, Modern Price: Russia’s Costly Admiral Nakhimov Upgrade
Russia has completed a costly, decade‑long modernization of the Kirov‑class battlecruiser Admiral Nakhimov, with estimates of up to $5 billion invested. The refit equips the 28,000‑ton nuclear‑powered ship with a new vertical launch system capable of firing up to 80 Kalibr or...

Imagine Communications Supports IP Migration at Rai
Italian public broadcaster Rai has awarded Imagine Communications a three‑year frame contract to deploy its Selenio Network Processor (SNP) as the core of its migration from SDI to IP across master and production control rooms. The SNP will act as...

Maritime Divide: Why the Philippines Is Failing Its Seas
Philippines’ maritime governance remains fragmented, leading to severe fisheries losses, safety failures, and costly logistics. Overfishing and weak enforcement cause an annual loss of about 45 million kilograms of fish, while ferry disasters like the MV Trisha Kerstin 3 highlight systemic safety...

South Korean Shipyard Joins U.S. Navy Ship Repair Program
South Korean shipbuilder SK Oceanplant signed a Master Ship Repair Agreement with the U.S. Navy. The agreement, granted after passing a NAVSUP port security assessment, authorizes the yard to compete for maintenance, repair and overhaul contracts on U.S. warships. SK...

Future-Ready Navigation for Naval Operations: SYNAPSIS Delivers a Unified and Integrated Platform for Modern Naval Missions
Anschütz unveiled SYNAPSIS, a unified, sensor‑agnostic navigation and tactical platform for modern warships. The system consolidates chart, sensor, and combat data into a single maritime picture via its Consistent Common Reference System, enhancing situational awareness and decision speed. SYNAPSIS WECDIS NX...

ARC Forum Day Two: Why Supply Chain Coordination Matters More Than Optimization
Day two of the ARC Forum highlighted that supply‑chain success now hinges on coordination rather than isolated optimization. While many firms have fine‑tuned transportation routes, inventory targets, and production schedules, overall performance remains erratic. Participants observed that decisions that look...

Will Move Tribunal Against MERC Tariff Order: Expert
MSEDCL has petitioned the Maharashtra Electricity Regulatory Commission (MERC) to review its multi‑year tariff, prompting a public hearing that drew industry, consumer and expert criticism. Participants warned that the proposed tariff could lift electricity costs by 25‑30%, endangering MSME profitability...

Haugland and Watson Terminal Services Ink NY Pact
Haugland Group and Waterson Terminal Services have signed a memorandum of understanding to develop New York ports for offshore wind projects. The deal merges Haugland’s marine construction, infrastructure, and logistics expertise with WTS’s terminal operations and cargo handling capabilities. Announced at...

South Korea Moves Closer to KDDX Stealth Destroyer Deal
South Korea’s Defense Acquisition Program Administration (DAPA) held a pre‑bid briefing on Feb 11 to launch the contractor‑selection phase for the Korean Next‑Generation Destroyer (KDDX). The program targets an 8,000‑ton stealth destroyer equipped with the Korean Vertical Launching System (KVLS) for...

LeBlanc + Smith Brings The Chloe to Nashville
LeBlanc + Smith, a New Orleans hospitality group, has launched The Chloe boutique hotel in Nashville. Housed in two restored 1920s Craftsman cottages that once housed Asylum Records, the property offers 19 guest rooms, an all‑day restaurant, three bars, a...

Eight Biotech Companies Spearheading the Antibody Drug Conjugate New Wave
A new wave of eight biotech firms is redefining antibody‑drug conjugates (ADCs) by pursuing unconventional targets, advanced linker chemistries, and novel cytotoxic payloads. Companies such as Adcendo, Adcentrx, and Tubulis are advancing phase 1/2 programs that address sarcoma, Nectin‑4, NaPi2b, and...
Developing a Risk-Scoring Tool for Artificial Intelligence-Enabled Biological Design
Researchers at RAND released a risk‑scoring framework to evaluate AI‑enabled biological design threats. The tool separates biological modification impact across five functions—host range, replication, immune evasion, environmental stability, and transmission—and an actor capability dimension that gauges technical skill and AI...

An FTA No One Is Talking About Can Give India a Strategic Edge
The India‑Chile free trade negotiations are moving toward a Comprehensive Economic Partnership Agreement that explicitly includes critical minerals such as lithium, copper, and cobalt. Chile’s abundant reserves could supply India’s “Make in India” and clean‑energy ambitions, while recent moves by...

Commonwealth Bank of Australia (CMWAY) Q2 2026 Earnings Call Transcript
Commonwealth Bank of Australia reported a solid second‑half 2025 performance, with cash net profit climbing 6% and earnings per share increasing $0.19. The bank highlighted disciplined growth across its core retail and business segments despite cost‑of‑living pressures and global uncertainty....

World Defense Show 2026: Russia Reveals Details of New Loitering Munition
At the World Defense Show 2026 in Riyadh, Kalashnikov unveiled the RUS‑PE loitering munition, a cannister‑launched, man‑portable system with an approximate 40 km range. The company said the weapon is already in service and entering low‑rate initial production, while development continues...

Chinese J-35 Face Engine Restrictions on Fujian Carrier
China’s carrier‑based J‑35 stealth fighters on the new Type 003 carrier Fujian are reported to suffer severe engine performance limits, restricting them to roughly seven minutes of flight at a 900 km radius. Analysts say the aircraft still rely on the older...

BMW and Eon Cooperate on V2G: BMW and Eon Launch First Commercial Vehicle-to-Grid Offering in Germany
BMW Group and energy provider Eon have introduced Germany’s first commercial vehicle‑to‑grid (V2G) offering for private customers. The package includes a bidirectional Wallbox Professional, a dedicated V2G electricity tariff, and a smart meter, initially targeting BMW’s Neue Klasse models such...

Korean Power Player Takes Stake in 390MW Sinan Ui
Korea Midland Power has committed €890 million to acquire a 96.1 million‑share stake in the 390 MW Sinan Ui offshore wind farm off South Jeolla Province. The project, part of a €1.9 billion development, targets commercial operation by February 2029 and will supply power to roughly...

The High Cost of Going Cashless: Why Payment Choice Is Essential for Economic Equity
The push toward a cashless economy is accelerating, but the hidden fees and infrastructure demands are creating a financial burden for low‑income and unbanked consumers. As merchants adopt digital terminals and fintech platforms expand, cash‑only transactions become increasingly costly or...

Polaris Deploys over 1 Million Smart Metres Under RDSS
Polaris Smart Metering announced the deployment of more than one million smart meters across India under the government’s Revamped Distribution Sector Scheme (RDSS). The rollout enhances billing accuracy, reduces AT&C losses, and provides granular data for grid operators to manage...

India’s Solar Boom Hits Module Glut, Upstream Gaps Persist: Report
India's solar module capacity has surged to about 144 GW and is projected to reach 180 GW by FY30. However, upstream segments lag, with cell capacity stuck near 23.4 GW, creating a supply‑demand mismatch as installations are expected at only 45‑50 GW annually. The...

DARPA Picks Saronic for Semi-Autonomous Vessel Protection Program
The Defense Advanced Research Projects Agency (DARPA) has chosen Saronic to lead the Pulling Guard program’s Focus Area 2, developing a semi‑autonomous, modular escort vessel for unarmed logistics ships. The platform will feature standardized physical and digital interfaces, allowing rapid integration...